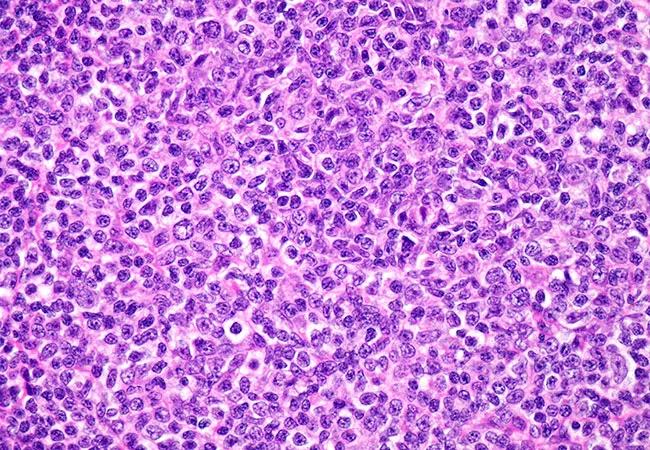

Study assesses outcomes of therapies with novel agents
Image content: This image is available to view online.
View image online (https://assets.clevelandclinic.org/transform/c612c71d-6a56-43f9-883f-272d93c53a6e/QD-Follicular-Lymphoma-WINTER_jpg)
QD-Follicular-Lymphoma-WINTER
Patients with relapsed follicular lymphoma who receive lenalidomide and a monoclonal antibody have better outcomes compared to those treated with PI3K inhibitors, according to data presented at the 2019 American Society of Hematology annual meeting.
Advertisement
Cleveland Clinic is a non-profit academic medical center. Advertising on our site helps support our mission. We do not endorse non-Cleveland Clinic products or services. Policy
“Follicular lymphoma is a lymphoma that we don’t consider curable,” says Cleveland Clinic Cancer Center hematologist Allison Winter, MD. “There are several established strategies in first-line therapy, but when people relapse, which we know most will at some point, there’s no standard approach for what to do next or how to sequence therapies.”
In an effort to identify the best approach for these patients, Dr. Winter and colleagues conducted a retrospective analysis of outcomes based on how novel therapies are sequenced in a clinical setting.
The study included 98 adult patients with follicular lymphoma who received commercially available novel agents at Cleveland Clinic and 10 other U.S. academic cancer centers.
There was a median time of 12 months from the end of the last follicular lymphoma treatment to the initiation of the first novel agent. Between the two groups there was no significant difference in the number of prior therapies, with a median of two (range 1-8), the researchers reported.
Forty-eight patients (49%) received lenalidomide with or without a monoclonal antibody. Fifty (51%) were treated with a PI3K inhibitor alone or in combination with a monoclonal antibody. The most commonly used PI3K inhibitor was idelalisib (n=47) followed by copanlisib (n=2) and duvelisib (n=1).
In the lenalidomide arm, five patients did not receive a monoclonal antibody while 39 were treated with rituximab and four with obinutuzumab. In comparison, 38 patients received a PI3K inhibitor alone; 12 were treated with a PI3K inhibitor plus rituximab.
Advertisement
For all patients, the median progression-free survival (PFS) and overall survival (OS) were 10 months and 120 months, respectively.

Image content: This image is available to view online.
View image online (https://assets.clevelandclinic.org/transform/682ec753-33a1-4b4a-b72a-4b9e9d841365/QD-Inset-2-All-Patients-OS-and-PFS-Color_jpg)
Figure 1. Probability of overall survival (OS) and progression-free survival (PFS) among all patients after novel agent treatment.
Looking at the individual cohorts, the researchers found that patients who received lenalidomide and a monoclonal antibody as the first novel agent had a significantly longer PFS compared to those who received PI3K monotherapy (15 vs. 6 months, p = 0.016). OS also was longer among the lenalidomide-plus-monoclonal antibody group (120 vs. 37 months, p = 0.002).

Image content: This image is available to view online.
View image online (https://assets.clevelandclinic.org/transform/260d6642-e528-4640-9f9d-4e812ec6af21/QD-Inset-3-Len-mAB-and-PI3Ki-mono-OS-color_jpg)
Figure 2. Probability of overall survival by novel agent treatment type.

Image content: This image is available to view online.
View image online (https://assets.clevelandclinic.org/transform/8d2d36fa-acf5-40a4-8601-e79aaaad6ad6/QD-Inset-1-Len-mAB-and-PI3Ki-mono-PFS-color_jpg)
Figure 3. Probability of progression-free survival by novel agent treatment type.
Reasons for the discontinuation of treatment varied significantly between the two groups. Patients in the PI3K inhibitor ± monoclonal antibody cohort were more likely than the lenalidomide ± monoclonal antibody group to halt treatment due to toxicity (40% vs. 28%, respectively) and transformed disease (15% vs. 3%).
The study’s findings suggest that lenalidomide plus a monoclonal antibody is superior to PI3K inhibitors as the first novel agent in the relapsed setting, according to Dr. Winter. However, she notes that there is an important caveat.
“There were quite a number of patients who had to discontinue therapy because of the toxicity of the PI3K inhibitor idelalisib,” Dr. Winter explains. “Since its approval, several other PI3K inhibitors have also been approved that are thought to have less toxicity.
Advertisement
“Because the majority of the patients received idelalisib, conclusions about other available PI3K inhibitors cannot be drawn,” she says. “Future analysis is required for these agents, and to determine the most effective sequence of therapies.”
The findings, while limited by the study’s retrospective design, offer valuable insight into this patient population. They also raise important questions.
“We don’t currently have any consensus or standard of care on how we should sequence therapies,” Dr. Winter says. “And, unfortunately, we don’t have prospective data to guide us, which is the gold standard. However, despite the limitations of a retrospective study, these findings are significant because they shed light on an area with limited data.
“It prompts us to delve deeper,” she adds. “A retrospective analysis is supposed to be thought-provoking and hypothesis-generating.”
For instance, why did the lenalidomide arm have longer PFS and OS? “We want to tease out the various factors, which brings us back to idelalisib and the rates of discontinuation,” Dr. Winter says. “A drug can’t work if you can’t take it. And so, if we look at the newer PI3K inhibitors, would the survival difference between the two groups still hold? If there were less toxicity and people were staying on PI3K inhibitors, would that difference in outcomes still stand true?
“That is something to look at moving forward and one of the thought-provoking questions that came out of this study,” she says.
Prospective head-to-head comparisons are ideal, but with the rapid pace of drug development and approvals, real-world experiences like this retrospective study can offer important insights.
Advertisement
“Working in collaboration to create more databases of treatment outcomes will help us expand our understanding of what is most effective and tolerable, and will provide clinicians in the community with the information they need to choose the right agent for their patients,” Dr. Winter says.
Advertisement
Advertisement
Creating a safe space for patients
Long-term immune effects reshape preventative strategies and timelines
Large-scale database also reveals potential for immunotherapy to protect against cancer
Findings may help guide discussions around prognosis and allogeneic stem cell transplantation
Research underscores the importance of access to timely diagnosis and treatment in this patient population.
A Cleveland Clinic model combining clinical staging, genomics and AI predicts survival with 18% greater accuracy — and could help match patients to more effective treatments.
Study serves as ‘cautionary tale’ for physicians tempted to rely on liquid biopsy results alone
Direct delivery of viral-based vector KB707 to the lungs may boost anti-tumor response and help overcome immune checkpoint inhibitor resistance